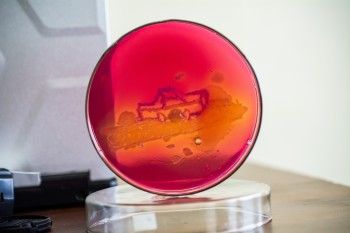
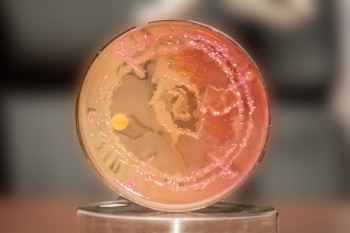

International Microorganisms Day is a worldwide event to promote the diversity and variety of microorganisms. It is a way to encourage everyone to recognize and celebrate the many ways microscopic organisms are important in human health, culture, economic activity, employment, and, throughout our daily lives. This year, the Department of Biological Sciences, with the generous support of the American Society for Microbiology (ASM) marked the day on 19th September 2025 at the University Eldoret Grounds to educate the public about the importance of microbes and microbiology in human welfare. The theme of the event was ‘Impact of the invisible World.’ The objectives of the event were to create awareness of the importance of microbes and microbiology in human welfare, to collaborate and network with national and international scientific organizations, to bring fun into learning Microbiology for students and invited participants, and to motivate and inspire the current Microbiology students of the University of Eldoret in their discipline.
The organization of this event was spearheaded by Dr. Becky Aloo from the Department of Biological Sciences and Marystella Injete, current Young Ambassador of ASM-Kenya, and Dr. Emily Chemoiwa, in collaboration with Microbiology technical staff and Microbiology students of UoE through the Microbiology students Association. The event was graced by Dr. Salina Rono, Ag. HOD, Department of Biological Sciences, and Prof. Donald Otieno, Dean of the School of Science who fficially opened the workshop.
The event involved many fun learning activities to spur interest among participants in Microbiology. Some of the activities that took place were the Agar Art show and competition, Microbiology Lab Demos, Microscopy Workshop, Meet the Microbes Poster Competition, Dance with Microbes, and Cut-the-Microbe Cake. There was a keynote speech on ‘Antimicrobial resistant Era’ which was delivered by Prof. Maurice Okoth, Ag. Director Openand Distance E-Learning (ODEL). The event culminated in awards to students who took part in various activities to promote microbial sciences, guests, and the organizing committee members. Below are some photos from the event.